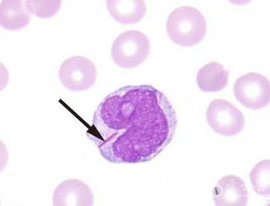
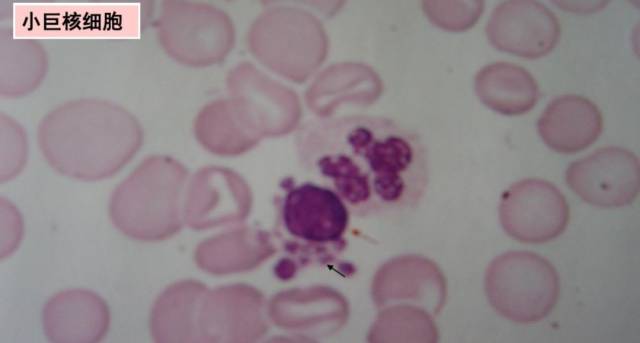

AUER小体
AUER小体
270x206 - 6KB - JPEG
 无auer小体
无auer小体
500x375 - 31KB - JPEG
 Auer小体增多,往往提示急性早幼粒细胞
Auer小体增多,往往提示急性早幼粒细胞
252x159 - 10KB - JPEG
 (23)2014年第2次血细胞形态学室间质量评价
(23)2014年第2次血细胞形态学室间质量评价
554x291 - 203KB - PNG
砒霜能治病,错怪了潘金莲?
750x1000 - 48KB - JPEG
砒霜能治病,错怪了潘金莲?
750x1000 - 48KB - JPEG
 看图识细胞之卫生部2018年第2次血细胞
看图识细胞之卫生部2018年第2次血细胞
701x472 - 71KB - JPEG
卫生部临床检验中心2018年第2次血细胞
640x485 - 63KB - JPEG
MDS的分类更新了!(9版VS8版教材)
MDS的分类更新了!(9版VS8版教材)
640x342 - 12KB - JPEG
砒霜能治病,错怪了潘金莲?
750x1000 - 34KB - JPEG
ICSH外周血细胞形态特征的命名和分级
481x324 - 26KB - JPEG
 显微镜下练就的火眼金睛--一例极早期
显微镜下练就的火眼金睛--一例极早期
650x326 - 31KB - JPEG
 病例学习:被误诊的急性早幼粒细胞白血病
病例学习:被误诊的急性早幼粒细胞白血病
188x329 - 12KB - JPEG
 一例非典型AML-M3
一例非典型AML-M3
520x211 - 30KB - JPEG
 急性未分化白血病
急性未分化白血病
1616x1216 - 5757KB - BMP